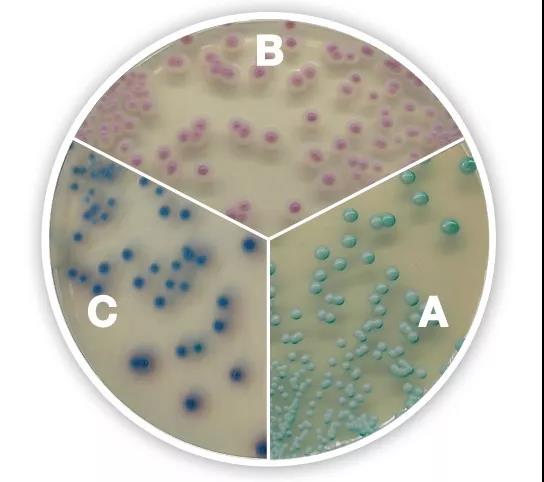

查看更多
密码过期或已经不安全,请修改密码
修改密码
壹生身份认证协议书
同意
拒绝
同意
拒绝
同意
不同意并跳过
近日,浙江一位王先生因为耳部疼痒来医院就诊,经医生检查后发现,王先生耳道内竟长满了黑色“苔藓”,了解病情后接诊的陈医生判断是王先生平常掏耳朵过勤或者使用的掏耳勺不干净损伤耳道才引发了真菌感染。

光明网

外耳道真菌病耳镜下表现
01
耳屎:掏还是不掏
“脏脏的”耳屎,其实大有作用,不能总掏,也不能不掏,多久掏,因人而异!
耳屎学名耵聍,组成成分为耳道分泌物、灰尘及角化脱落细胞等,由于自身的油性成分能够起到润滑、湿润耳道、避免干燥的作用,一定程度上抵抗了细菌、病毒的侵害。此外,由于能够粘住外界误入耳道的灰尘颗粒、昆虫,还能对声波起到过滤及缓冲作用,一方面可以阻挡异物入侵,另一方面也能保护耳膜功能不被损伤。多数情况下,由于耳道内固有的清洁作用,耳屎不会累积过多,只有在少数感染、堵塞耳道的情况,才需要到医院由医生处理。
02
采耳当谨慎
耳真菌病又称外耳道真菌病,由耳道皮肤毛囊浅部真菌感染所致,病因尚不明确,常见症状包括耳部奇痒、耳痛、溢液、听力障碍等,不当掏耳行为、习惯性洗耳、不洁净的泳池游泳或洗澡水长时间浸泡耳道都可能破坏耳道耵聍腺,易造成耳道皮肤损伤,是本病的最常见诱因,此外,老年后因免疫力降低、耳道自净能力下降及油脂腺分泌旺盛人群也是本病的高风险人群。
03
这些部位,真菌爱打扰
真菌在我们生活环境中和身体上都有广泛存在,只不过多数时候以静息状态存在,并不会对人体构成威胁,但遇到适宜的生长环境或人体免疫力降低时就可能引发疾病,生活中常买的蘑菇、家里水槽边角泛出的绿色苔藓都是它们的身影,因为我们的外耳道比较偏僻,通风不好,加上包裹皮肤又特别娇弱,容易损伤及储留水分,而真菌又偏爱潮湿、偏酸的环境,所以和常年裹在鞋里的脚丫子、女性阴道一样,都是因为有类似情况而成为人体真菌感染的重灾区。
04
缉拿“真”凶
能引起外耳道真菌病的菌属包括曲霉菌、念珠菌、假丝酵母菌和青霉菌等,由于不同菌属的生长习性及对药物敏感性均存在较大差异,故明确病原菌类型,对于精准用药及临床治疗都有着重要意义,常用检测手段包括显微镜观察和真菌培养两种:
看:
KOH压片显微镜检查因其简便、快速而成为应用最为普遍的真菌检查法。氢氧化钾能够软化、消化和清除真菌周围的组织(如皮肤中角蛋白),并能清除标本中的脓细胞而不破坏真菌菌丝和孢子。因此KOH可作为直接检查的首选试剂。
浓度要求:10%KOH用于角质层较薄的皮屑,20%的KOH则用于角质层较厚的皮屑、甲屑和毛发。镜下找到菌丝或孢子即可发出阳性报告,缺点是不能明确致病菌种,临床上多用于筛查。
操作步骤:将标本(毛发、甲屑、分泌物等)置载玻片上,加1滴10%-15%KOH溶液,加盖片后用手轻压,快速通过酒精灯火焰几次以促进角质溶解,吸水纸吸除盖片周围溢液,置光学显微镜下观察。
白色念珠菌(A)、克柔念珠菌(B)、热带念珠菌(C)科马嘉培养基上菌落特征
种:
即真菌培养,标本接种到营养培养基上面或里面,孵育至标本中有真菌生长,沙保罗培养基是目前临床实验室最常用基础培养基,此外可以借助科玛嘉显色培养基来快速辅助判断菌株类型,分纯后念珠菌菌落经适当稀释后可通过全自动微生物鉴定仪鉴定型别;曲霉菌感染目前实验室检测手段比较有限,因其培养时间较长,且易受到环境的污染,这就有可能延误最佳治疗时机。早期诊断主要依赖于菌落形态、镜下结构特征、菌落颜色等形态学特征人工判断。
来源:检验医学
查看更多